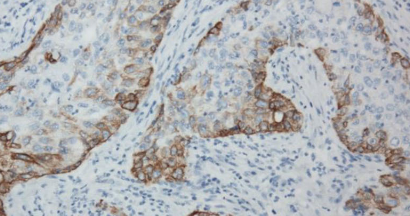

Molecular classification of muscle-invasive bladder cancer based on a simplified immunohistochemical panel using GATA3, CK5/6 and p16
DOI:
https://doi.org/10.17305/bb.2023.9242Keywords:
Urothelial carcinoma, bladder cancer, immunohistochemistry (IHC), molecular subtype, survival analysisAbstract
The choice of therapy for muscle-invasive bladder cancer (MIBC) could be influenced by the tumor’s molecular subtype. Currently, well-defined consensus subtypes are based on tumor microarray mRNA data. Clearly defined and easy-to-use surrogate molecular subtypes, based on immunohistochemistry (IHC) performed on whole slides, are needed to make subtyping cost-effective and useful in routine work and future research. To aid in the development of a simple immunohistochemical classifier, a retrospective single-center series of 92 cases of localized bladder cancer was identified. Routine IHC for GATA3, cytokeratins 5 and 6 (CK5/6), and p16 was performed on whole tissue blocks containing muscle-invasive disease. Electronic medical records were retrieved and searched for clinical variables, treatment, and survival data. The mean age was 69.6 years, and 73% were males. Conservative treatment was used in 55% of cases, while cystectomy with chemotherapy was used in 45%. GATA3 and CK5/6 expression divided cases into broad luminal and basal subtypes, respectively, while p16 expression was used to subclassify luminal cases into luminal papillary and luminal unstable types according to the consensus molecular classification. When subtyped in this way, GATA3 and CK5/6 negative cases showed worse overall survival. Molecular subtyping of MIBC on whole slides containing muscle-invasive tumor using only three commonly used, consensus-based antibodies, is a feasible and cost-effective method for detecting subtypes of invasive bladder cancer. Future work combining morphological analysis and IHC is needed to fully translate the consensus molecular classification into a comprehensive, cost-effective subtyping strategy.
Citations
Downloads
Downloads
Additional Files
Published
Issue
Section
Categories
License
Copyright (c) 2023 Robert Terlević, Monika Ulamec, Goran Štimac, Jure Murgić, Božo Krušlin

This work is licensed under a Creative Commons Attribution 4.0 International License.
How to Cite
Accepted 2023-06-14
Published 2023-11-03









